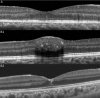

Hyperreflective Stress Lines and Macular Holes
- PMID: 32347919
- PMCID: PMC7401923
- DOI: 10.1167/iovs.61.4.50
Hyperreflective Stress Lines and Macular Holes
Abstract
Purpose: To determine the prevalence of a central hyperreflective line in eyes with full-thickness macular holes (FTMH) and lamellar macular holes (LMH) and to elucidate the pathoanatomic importance of this optical coherence tomography (OCT) sign.
Methods: This retrospective analysis evaluated patients with FTMH and LMH at the Stein Eye Institute. Clinical data was collected and SD-OCT volume scans were analyzed for the presence of a central vertical hyperreflective line in 3 separate cohorts: patients with SD-OCT preceding FTMH development, patients with SD-OCT after pars plana vitrectomy (PPVT) treatment for FTMH, and patients with SD-OCT of LMH.
Results: In total, 93 eyes with FTMH and 88 eyes with LMH were identified. Of the 93 FTMH eyes, SD-OCT volume scans were available before development of the FTMH in 12 eyes. Of these, 6 (50%) displayed a vertical hyperreflective line preceding the development of the FTMH. Fifty-one eyes underwent PPVT with resolution of the FTMH, and 26 displayed a hyperreflective line after resolution (51%). Of the 88 eyes with LMH, 22 displayed a hyperreflective line (25%). All hyperreflective lines were noted at the central fovea.
Conclusions: SD-OCT illustrated the presence of a central vertical hyperreflective line preceding FTMH and after resolution of FTMH after PPVT in approximately one-half of cases, and concurrent with LMH in 25% of cases. This vertical hyperreflective line may represent an early SD-OCT marker for the development of FTMH, and may be a sign of central foveal dehiscence owing to disruption of the Muller cell cone.
Conflict of interest statement
Disclosure:
Figures

References
Publication types
MeSH terms
LinkOut - more resources
Full Text Sources
Miscellaneous

